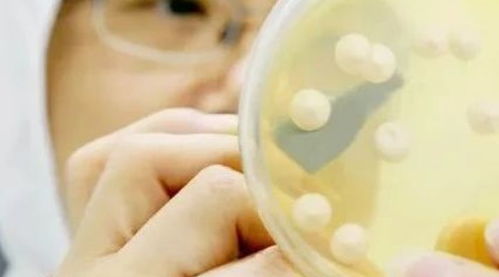
常用菌種保藏方法有哪些

菌種保藏是食用菌產(chǎn)業(yè)的一項(xiàng)基礎(chǔ)工作,是確保野生種質(zhì)資源基因留存和現(xiàn)有生產(chǎn)用種遺傳性能相對(duì)穩(wěn)定的必要手段。
菌種保藏的方法多種多樣,有的雖然保藏效果好,但投資高或操作繁雜。在生產(chǎn)實(shí)踐中,更需要設(shè)備投入少,能保障菌種不死亡、不污染、最大限度地保持優(yōu)良種性的簡(jiǎn)便方法,如斜面低溫短期保藏和自然基質(zhì)較長(zhǎng)期保藏相結(jié)合的方法。
一般而言,對(duì)母種進(jìn)行長(zhǎng)期保存,對(duì)原種進(jìn)行短期保存。須保證優(yōu)良菌種的性狀和活力不發(fā)生變異,不死亡,不被污染,確保其純度。
因此,保存方法應(yīng)具備取材容易、操作方便、菌種不易退化、長(zhǎng)期保存不污染雜菌等優(yōu)點(diǎn)。常用的菌種保存方法如下:(一)斜面低溫保藏 該法的優(yōu)點(diǎn)是保藏方便且所占空間較小。
具體做法是:菌絲長(zhǎng)滿斜面后,放在0~5℃保存。以后每隔一定時(shí)間(2~3個(gè)月)轉(zhuǎn)管一次。
轉(zhuǎn)管保存不能長(zhǎng)期用PDA培養(yǎng)基,否則種性易退化,灰樹花降解木質(zhì)纖維素的能力減弱。因此隔一定時(shí)間(1年左右)須把菌種轉(zhuǎn)接到木屑培養(yǎng)基上復(fù)壯,之后挑選健壯無污染的菌絲再轉(zhuǎn)回PDA培養(yǎng)基保存。
在長(zhǎng)期保存過程中,要防棉塞受潮滋生雜菌。菌種試管口最好用蠟燙封,以防培養(yǎng)基內(nèi)水分過快蒸發(fā)。
增加瓊脂用量(2.5%~3%)可減緩水分蒸發(fā)。還要防止菌種管上的標(biāo)簽脫落而造成種系混雜。
斜面低溫保藏方法簡(jiǎn)便易行,能隨時(shí)觀察保藏菌株的活力和純度,一旦染雜,肉眼能及時(shí)發(fā)現(xiàn)。(二)自然基質(zhì)保藏 此法是根據(jù)灰樹花的特性,利用自然基質(zhì)保藏其菌種的方法。
灰樹花是木腐菌,可以采用以木屑為主料的培養(yǎng)基。自然基質(zhì)營(yíng)養(yǎng)全面,且大部為緩釋養(yǎng)分,不易產(chǎn)生營(yíng)養(yǎng)過剩或饑餓;其次,培養(yǎng)基理化性狀好,可吸收或緩沖菌絲代謝出的有害物質(zhì),水分與通氣協(xié)調(diào)平衡,部分菌絲扎入基質(zhì)內(nèi)生長(zhǎng),不裸露于空氣中,菌絲呼吸強(qiáng)度低,生命力強(qiáng)。
1.原料與配方 粗、細(xì)木屑比例適當(dāng),采用板栗樹木屑最佳,粗木屑粒徑為2毫米左右,細(xì)木屑為一般圓盤鋸屑,粗、細(xì)的比例為1∶2,添加干木屑重量20%的麩皮和1%的糖,含水率為60%左右。這樣的基質(zhì)通氣性好,營(yíng)養(yǎng)豐富且供菌絲分解利用的時(shí)間長(zhǎng),長(zhǎng)到基質(zhì)內(nèi)部的菌絲比包裹在基質(zhì)外部暴露于空氣中的菌絲耐受性強(qiáng)。
不同粒徑的基質(zhì)比例適當(dāng),還能協(xié)調(diào)氣與水的矛盾。粗粒過多,架空菌絲多;細(xì)粒過多,透氣性差,菌絲生長(zhǎng)慢。
應(yīng)用配方如下:栗木屑78%,麩皮20%,石膏1%,蔗糖1%,水65%配料,裝入較粗大的試管中,裝料量為試管的1/3~1/2,1.5千克/厘米2滅菌1.5小時(shí)。冷卻后,接入需保藏的菌種,在28℃下培養(yǎng),待菌絲長(zhǎng)滿木屑培養(yǎng)基時(shí)取出換上無菌橡皮塞,在0~5℃冰箱內(nèi)保藏1~2年轉(zhuǎn)管一次。
2.容器與裝量 采用容量250毫升的葡萄糖玻璃瓶,清洗潔凈,裝量一般不超過玻璃瓶容量的3/5,填料不能過滿,瓶壁所殘留的顆粒須擦拭干凈,否則保藏的菌種易引起污染。3.滅菌和冷藏 滅菌時(shí)若采用棉塞封口,基質(zhì)表層易失水,接種成活率低,即使菌絲復(fù)活,生長(zhǎng)也很緩慢,所以最好采用聚丙烯膜封口,接種后換用無菌棉塞培養(yǎng),待菌絲長(zhǎng)滿后再換成有孔滅菌膠塞冰箱保藏。
用上述方法保藏的菌種經(jīng)3年貯放后,接出成活率均達(dá)90%以上,出菇驗(yàn)證產(chǎn)量及子實(shí)體形態(tài)特征均無明顯變化。因此,自然基質(zhì)保藏法具有保存期長(zhǎng),菌種遺傳性能相對(duì)穩(wěn)定的特點(diǎn)。
(三)木粒PDA斜面保藏 灰樹花在自然狀態(tài)下易發(fā)生于栗樹根部,這說明其營(yíng)養(yǎng)需求較為特殊。根據(jù)灰樹花這種習(xí)性,在PDA基礎(chǔ)上添加適量的栗樹木粒制成母種培養(yǎng)基。
在多年的使用中發(fā)現(xiàn),用該培養(yǎng)基培養(yǎng)的母種生長(zhǎng)勢(shì)好,在轉(zhuǎn)接原種時(shí),適應(yīng)能力強(qiáng),萌發(fā)定植快;用作菌種保藏基質(zhì)時(shí),保藏時(shí)間長(zhǎng),并能很好保持菌種的優(yōu)良性狀。1.木粒PDA的制作 選取栗樹邊材,加工成0.3~0.5厘米的顆粒,及時(shí)烘干或曬干備用。
稱取葡萄糖10克,KH2PO41克,1溶解于1升清水中配制成營(yíng)養(yǎng)液。將營(yíng)養(yǎng)液倒入盛有木粒的小鋁鍋中,營(yíng)養(yǎng)液以完全浸沒木粒為準(zhǔn)。
煮沸10分鐘,以加快木粒對(duì)營(yíng)養(yǎng)液的吸收速度,起鍋靜置30分鐘讓木粒吸足營(yíng)養(yǎng)液。撈出木粒,瀝掉表面的水,裝入試管,裝量為試管長(zhǎng)的1/6,最多不得超過試管長(zhǎng)的1/5,否則在擺制斜面時(shí),不易使木粒均勻分散于斜面的表面上。
選取新鮮的馬鈴薯,去皮并切成薄片,稱取200克放入小鋁鍋中,加入1升清水,文火煮沸30分,趁熱過濾取汁,并補(bǔ)足1升的體積。稱取瓊脂20克,葡萄糖20克,KH2PO4 2克,MgSO47H2O 2克。
先將瓊脂剪碎,加入到馬鈴薯濾液中,繼續(xù)用文火加熱,使瓊脂溶化。待瓊脂完全溶化后,加入稱好的其他3種營(yíng)養(yǎng)成分,攪拌使這些物質(zhì)溶解均勻,趁熱裝入已裝有木粒的試管中,裝至試管長(zhǎng)的1/3處,塞上棉塞。
在0.8~1千克/厘米2蒸氣壓下滅菌40分,待氣壓降至0時(shí),開蓋取出,趁熱輕輕抖拍試管,使木粒分散后即可擺制斜面,并使木粒呈半裸狀分布于斜面上,待凝固后便制成了木粒PDA培養(yǎng)基。2.生長(zhǎng)及保藏效果 木粒PDA斜面上培養(yǎng)的灰樹花母種,菌絲生長(zhǎng)迅速、良好,12天即可長(zhǎng)滿試管,但菌絲的后期生長(zhǎng)勢(shì)更為粗壯、濃密,后勁足。
轉(zhuǎn)接原種時(shí),菌種適應(yīng)力強(qiáng),定植快。這表明,灰樹花菌絲的生長(zhǎng)速度、生長(zhǎng)勢(shì)不僅取決于本身的遺。
1、傳代培養(yǎng)保藏法:包括又有斜面培養(yǎng)、穿刺培養(yǎng)、皰肉培養(yǎng)基培養(yǎng)等,培養(yǎng)后于4-6℃冰箱內(nèi)保存。
2、液體石蠟覆蓋保藏法:液體石蠟覆蓋保藏法是傳代培養(yǎng)的變相方法,能夠適當(dāng)延長(zhǎng)保藏時(shí)間。
3、載體保藏法:載體保藏法是將微生物吸附在適當(dāng)?shù)妮d體,如土壤、沙子、硅膠、濾紙上,而后進(jìn)行干燥的保藏法。
4、寄主保藏法:寄主保藏法用于目前尚不能在人工培養(yǎng)基上生長(zhǎng)的微生物。
5、冷凍干燥保藏法:先使微生物在極低溫度(-70℃左右)下快速冷凍,然后在減壓下利用升華現(xiàn)象除去水分(真空干燥),其中真空冷凍干燥法最常見。
擴(kuò)展資料
菌種保藏的原理:
菌種保藏有多種方法,其原理大多大同小異,主要是運(yùn)用一些方式盡量降低生物體內(nèi)的代謝,達(dá)到延長(zhǎng)生命,減少變異的目的。通常采用的方法為低溫、缺氧、干燥。
低溫主要對(duì)菌種產(chǎn)生兩方面的影響,首先,較低的溫度可以減緩機(jī)體細(xì)胞的酶活,降低新陳代謝,達(dá)到保藏菌種的目的。其次,低溫同時(shí)會(huì)導(dǎo)致菌體誘發(fā)菌絲自溶機(jī)制,如果降溫過程失誤,同樣會(huì)造成機(jī)體的機(jī)械損傷和溶質(zhì)損傷。
參考資料來源:百度百科——菌種保藏
菌種的優(yōu)劣是食用菌生產(chǎn)成敗的關(guān)鍵。菌種是國(guó)家重要的生物資源,也是微生物工廠首要的生產(chǎn)資料。由于微生物繁殖快、易變異,因此微生物菌種特別需要妥善保藏。世界各國(guó)對(duì)微生物菌種都很重視。中國(guó)科學(xué)院微生物研究所專門設(shè)立了菌種的保藏機(jī)構(gòu),為各生產(chǎn)單位收藏和供應(yīng)各種優(yōu)良菌種。當(dāng)然就具體的生產(chǎn)單位而言,大量的生產(chǎn)用菌種還得靠自己來生產(chǎn)和保藏。
菌種保藏的目的:是使優(yōu)良菌種經(jīng)過較長(zhǎng)時(shí)間后,仍能保持菌種的優(yōu)良性狀、生活能力及純度,降低菌種的衰亡速度,確保菌種的純一,防止雜菌污染及絕種。
保藏菌種的方法:人們?cè)陂L(zhǎng)期的生產(chǎn)實(shí)踐中,積累了不少保藏菌種的經(jīng)驗(yàn),常用的保藏方法有:斜面低溫保藏法、液體石蠟保藏法、砂土管保藏法、濾紙片保藏法、谷粒保藏法等。常用保藏菌種的方法有以下幾種:
(1)斜面低溫保藏法這是最簡(jiǎn)單最普通的保藏方法。首先將菌種在適宜的斜面培養(yǎng)基(一般PDA)上培養(yǎng)成熟后,選擇菌絲生長(zhǎng)粗壯,邊緣保存。一般保存溫度4~6℃,除草菇和銀耳菌種外(10~15℃),此方法對(duì)其他食用菌都適宜,一般菌種可保藏2~4個(gè)月,所以需定時(shí)移接。此法保藏雖然方便,但是保藏時(shí)間短,需經(jīng)常轉(zhuǎn)管,也很容易發(fā)生衰退變異現(xiàn)象。因此,不能用作長(zhǎng)期保藏,最好與其他方法結(jié)合起來保藏。
另外,為了減少保藏期間培養(yǎng)基水分蒸發(fā),瓊脂最好加到2.5%。為防止菌種在保藏過程中產(chǎn)酸分的積累,應(yīng)加入0.2%的磷酸氫二鉀、磷酸二氫鉀等緩沖鹽類,同時(shí),培養(yǎng)成熟后,最好將棉塞管口外剪平,并用礦蠟封或換以無菌木塞,這樣做也可以減少培養(yǎng)基水分的散失,延長(zhǎng)保存時(shí)間。
在農(nóng)村如果沒有冰箱,可采用土法保藏。即把保藏用的斜面菌種換上無菌橡皮塞,并用礦燭蠟封后密閉的廣口瓶中,懸入井底保藏。(2)貯藏室保藏法原種和栽培種一般只在貯藏室短期保藏,貯藏室溫度0~10℃為好。室內(nèi)應(yīng)清潔、干燥、無光,應(yīng)經(jīng)常檢查溫度和濕度,以降低其生活力,減少變異退化,防止雜菌污染,避免過早出菇。溫度越高,保存的時(shí)間越短。
菌種保藏方法大全 基本原理 微生物具有容易變異的特性,因此,在保藏過程中,必須使微生物的代謝處于最不活躍或相對(duì)靜止的狀態(tài),才能在一定的時(shí)間內(nèi)使其不發(fā)生變異而又保持生活能力。
低溫、干燥和隔絕空氣是使微生物代謝能力降低的重要因素,所以,菌種保藏方法雖多,但都是根據(jù)這三個(gè)因素而設(shè)計(jì)的。 保藏方法大致可分為以下幾種: 1.傳代培養(yǎng)保藏法 又有斜面培養(yǎng)、穿刺培養(yǎng)、皰肉培養(yǎng)基培養(yǎng)等(后者作保藏厭氧細(xì)菌用),培養(yǎng)后于4—6℃冰箱內(nèi)保存。
2.液體石蠟覆蓋保藏法 是傳代培養(yǎng)的變相方法,能夠適當(dāng)延長(zhǎng)保藏時(shí)間,它是在斜面培養(yǎng)物和穿刺培養(yǎng)物上面覆蓋滅菌的液體石蠟,一方面可防止因培養(yǎng)基水分蒸發(fā)而引起菌種死亡,另一方面可阻止氧氣進(jìn)入,以減弱代謝作用。3.載體保藏法 是將微生物吸附在適當(dāng)?shù)妮d體,如土壤、沙子、硅膠、濾紙上,而后進(jìn)行干燥的保藏法,例如沙土保藏法和濾紙保藏法應(yīng)用相當(dāng)廣泛。
4.寄主保藏法 用于目前尚不能在人工培養(yǎng)基上生長(zhǎng)的微生物,如病毒、立克次氏體、螺旋體等,它們必須在生活的動(dòng)物、昆蟲、雞胚內(nèi)感染并傳代,此法相當(dāng)于一般微生物的傳代培養(yǎng)保藏法。病毒等微生物亦可用其他方法如液氮保藏法與冷凍干燥保藏法進(jìn)行保藏。
5.冷凍保藏法 可分低溫冰箱(-20—-30℃,-50—-80℃)、干冰酒精快速凍結(jié)(約-70℃)和液氮(-196℃)等保藏法。 6.冷凍干燥保藏法 先使微生物在極低溫度(-70℃左右)下快速冷凍,然后在減壓下利用升華現(xiàn)象除去水分(真空干燥)。
有些方法如濾紙保藏法、液氮保藏法和冷凍干燥保藏法等均需使用保護(hù)劑來制備細(xì)胞懸液,以防止因冷凍或水分不斷升華對(duì)細(xì)胞的損害。保護(hù)性溶質(zhì)可通過氫和離子鍵對(duì)水和細(xì)胞所產(chǎn)生的親和力來穩(wěn)定細(xì)胞成分的構(gòu)型。
保護(hù)劑有牛乳、血清、糖類、甘油、二甲亞砜等。 三、器材 細(xì)菌、酵母菌,放線菌和霉菌; 肉膏蛋白胨斜面培養(yǎng)基,滅菌脫脂牛乳,滅菌水,化學(xué)純的液體石蠟,甘油,五氧化二磷,河沙,瘦黃土或紅土,冰塊、食鹽,干冰,95%酒精,10%鹽酸,無水氯化鈣; 滅菌吸管,滅菌滴管,滅菌培養(yǎng)皿,管形安瓿管,淚滴形安瓿管(長(zhǎng)頸球形底),40目與 100目篩子,油紙,濾紙條(0.5*1.2cm),干燥器,真空泵,真空壓力表,噴燈,L形五通管,冰箱,低溫冰箱(-30℃),液氮冷凍保藏器。
四、操作步驟、各保藏法的應(yīng)用范圍及優(yōu)缺點(diǎn) 下列各法可根據(jù)實(shí)驗(yàn)室具體條件與需要選做。 1.斜面低溫保藏法 將菌種接種在適宜的固體斜面培養(yǎng)基上,待菌充分生長(zhǎng)后,棉塞部分用油紙包扎好,移至2—8℃的冰箱中保藏。
保藏時(shí)間依微生物的種類而有不同,霉菌、放線菌及有芽孢的細(xì)菌保存2—4個(gè)月,移種一次。酵母菌兩個(gè)月,細(xì)菌最好每月移種一次。
此法為實(shí)驗(yàn)室和工廠菌種室常用的保藏法,優(yōu)點(diǎn)是操作簡(jiǎn)單,使用方便,不需特殊設(shè)備,能隨時(shí)檢查所保藏的菌株是否死亡、變異與污染雜菌等。缺點(diǎn)是容易變異,因?yàn)榕囵B(yǎng)基的物理、化學(xué)特性不是嚴(yán)格恒定的,屢次傳代會(huì)使微生物的代謝改變,而影響微生物的性狀;污染雜菌的機(jī)會(huì)亦較多。
2.液體石蠟保藏法 (1)將液體石蠟分裝于三角燒瓶?jī)?nèi),塞上棉塞,并用牛皮紙包扎,1.05kg/cm2>,121.3℃滅菌30分鐘,然后放在40℃溫箱中,使水汽蒸發(fā)掉,備用。 (2)將需要保藏的菌種,在最適宜的斜面培養(yǎng)基中培養(yǎng),使得到健壯的菌體或孢子。
(3)用滅菌吸管吸取滅菌的液體石蠟,注入已長(zhǎng)好菌的斜面上,其用量以高出斜面頂端1cm為準(zhǔn)(圖Ⅶ-12),使菌種與空氣隔絕。 (4)將試管直立,置低溫或室溫下保存(有的微生物在室溫下比冰箱中保存的時(shí)間還要長(zhǎng))。
此法實(shí)用而效果好。霉菌、放線菌、芽孢細(xì)菌可保藏2年以上不死,酵母菌可保藏1—2年,一般無芽孢細(xì)菌也可保藏1年左右,甚至用一般方法很難保藏的腦膜炎球菌,在37℃溫箱內(nèi),亦可保藏3個(gè)月之久。
此法的優(yōu)點(diǎn)是制作簡(jiǎn)單,不需特殊設(shè)備,且不需經(jīng)常移種。缺點(diǎn)是保存時(shí)必須直立放置,所占位置較大,同時(shí)也不便攜帶。
從液體石蠟下面取培養(yǎng)物移種后,接種環(huán)在火焰上燒灼時(shí),培養(yǎng)物容易與殘留的液體石蠟一起飛濺,應(yīng)特別注意。 3.濾紙保藏法 (1)將濾紙剪成0.5*1.2cm的小條,裝入0.6*8cm的安瓿管中,每管1—2張,塞以棉塞,1.05kg/cm2>,121.3℃滅菌30分鐘。
(2)將需要保存的菌種,在適宜的斜面培養(yǎng)基上培養(yǎng),使充分生長(zhǎng)。 (3)取滅菌脫脂牛乳1—2ml滴加在滅菌培養(yǎng)皿或試管內(nèi),取數(shù)環(huán)菌苔在牛乳內(nèi)混勻,制成濃懸液。
(4)用滅菌鑷子自安瓿管取濾紙條浸入菌懸液內(nèi),使其吸飽,再放回至安瓿管中,塞上棉塞。 (5)將安瓿管放入內(nèi)有五氧化二磷作吸水劑的干燥器中,用真空泵抽氣至干。
(6)將棉花塞入管內(nèi),用火焰按圖Ⅶ-13熔封,保存于低溫下。 (7)需要使用菌種,復(fù)活培養(yǎng)時(shí),可將安瓿管口在火焰上燒熱,滴一滴冷水在燒熱的部位,使玻璃破裂,再用鑷子敲掉口端的玻璃,待安瓿管開啟后,取出濾紙,放入液體培養(yǎng)基內(nèi),置溫箱中培養(yǎng)。
細(xì)菌、酵母菌、絲狀真菌均可用此法保藏,前兩者可保藏2年左右,有些絲狀真菌甚至可保藏14—17年之久。此法較液氮、冷凍干燥法簡(jiǎn)便,不需要特殊設(shè)備。
4.沙土保藏法 。
菌種保藏方法很多,常用的有繼代培養(yǎng)低溫保藏、液體石蠟覆蓋保藏、蒸餾水覆蓋低溫保藏、超低溫冰箱保藏和液氮超低溫凍結(jié)保藏。
(1)繼代培養(yǎng)低溫保藏:將菌種放在4℃?6℃恒溫箱中保藏3?6個(gè)月,然后重新進(jìn)行移接,移接后再放回恒溫箱繼續(xù)保藏。此法是目前普遍采用的方法,優(yōu)點(diǎn)是應(yīng)用儀器設(shè)備簡(jiǎn)單,操作方便,簡(jiǎn)便易行。
缺點(diǎn)是菌種退化快,較長(zhǎng)時(shí)間保藏后常出現(xiàn)菌絲生長(zhǎng)緩慢,甚至不能生長(zhǎng)現(xiàn)象,有的品種還會(huì)形成色素。 (2)液體石蠟覆蓋保藏:將無菌的液體石蠟覆蓋于菌種斜面表面,隔絕菌種的氧氣供應(yīng),以控制生長(zhǎng),減緩老化,減少變異。
此法有時(shí)會(huì)出現(xiàn)大量分泌色素、發(fā)生角變、菌絲變稀變?nèi)酢⑸L(zhǎng)不正常等問題。 (3)蒸餾水覆蓋低溫保藏:將無菌蒸餾水注入需保藏菌種的斜面菌種內(nèi),然后把菌袋(瓶)直立放置于4℃?6℃恒溫箱保藏。
此法常被用作菌種的短期保藏,1年左右需要繼代培養(yǎng)1次。 (4)超低溫冰箱保藏:此法需要超低溫冰箱,溫度控制在-76℃?-80℃,可以長(zhǎng)期保藏。
(5)液氮超低溫凍結(jié)保藏:此法是將菌種置于保護(hù)劑中,經(jīng)程序降溫至-90℃,將菌種置于液氮容器中長(zhǎng)期保藏。
(1)斜面低溫保藏。是一種最常用、最簡(jiǎn)便的菌種保藏方法。首先將需要保藏的菌種接到斜面培養(yǎng)基上,在適宜的溫度條下培養(yǎng),當(dāng)菌絲健壯地長(zhǎng)滿斜面時(shí),即將此試管菌種取出,放置于4 ℃的冰箱中保藏。特點(diǎn):
①簡(jiǎn)單易行,適用于各類菇類菌種保藏,是目前生產(chǎn)及科研普遍采用的一種方法;②保藏時(shí)間短,需6個(gè)月轉(zhuǎn)接一次,轉(zhuǎn)管次數(shù)多菌絲變異的可能性大;③如改用橡皮塞并用石蠟扣,可保藏1年~3年。
(2)液體石蠟保藏。液體石蠟保藏也稱為礦油保藏,即用礦油覆蓋試管斜面試管保藏的方法。礦油是指無色、透明、黏稠、性質(zhì)穩(wěn)定、不易被微生物分解的石蠟油和液體石蠟,將其覆蓋在斜面菌種之上,可以隔絕空氣,防治培養(yǎng)基水分蒸發(fā),抑制微生物的代謝活動(dòng),推遲細(xì)胞老化,從而達(dá)到長(zhǎng)期保藏菌種的目的。特點(diǎn):
①方法簡(jiǎn)便易行,保藏條件不嚴(yán)格,保藏時(shí)間長(zhǎng),可作為長(zhǎng)期保藏菌種的方法;②菌種必須垂直放,放置不方便。
(3)濾紙保藏。濾紙保藏是一種以無菌濾紙作為食用菌孢子吸附載體長(zhǎng)期保藏菌種的方法,又稱濾紙孢子保藏法。特點(diǎn):技術(shù)要求高,設(shè)備費(fèi)用大,菌種不易衰老退化,菌種保藏時(shí)間長(zhǎng)很少變異。
(4)自然基質(zhì)保藏。自然基質(zhì)保藏就是以不含毒性、刺激性和抑菌性而富含營(yíng)養(yǎng)的自然生長(zhǎng)的基質(zhì)作培養(yǎng)基來保藏菌種的方法。自然基質(zhì)很多,食用菌常用的自然基質(zhì)有發(fā)酵的糞草、木屑及枝條基質(zhì)等,取材方便,制作方法簡(jiǎn)便,保藏時(shí)間也較長(zhǎng)。使用時(shí),只需取一塊、一粒或一條培養(yǎng)物放在新鮮的培養(yǎng)基上,并在適溫下培養(yǎng)即可。特點(diǎn):方法簡(jiǎn)便易行,保藏時(shí)間長(zhǎng)。
為了保持菌種的純凈,常需要進(jìn)行 菌種的保藏。
菌種的保藏分為臨時(shí)保藏 和長(zhǎng)期保藏。 1. 臨時(shí)保藏 臨時(shí)保藏常用于頻繁使用的菌種。
首先將菌種接種到試管的固體斜面培養(yǎng) 基上,在合適的溫度下培養(yǎng)。當(dāng)菌落長(zhǎng) 大后,將試管放入4 °c的冰箱中保藏。
以后每3?6個(gè)月,都要重新將菌種從舊 的培養(yǎng)基上轉(zhuǎn)移到新鮮的培養(yǎng)基上。不 過此方法保存時(shí)間不長(zhǎng),菌種容易被污 染或產(chǎn)生變異。
2. 長(zhǎng)期保藏 長(zhǎng)期保藏常用于需要長(zhǎng)期保存的菌 種,采用的是甘油管藏的方法。在3 mL 的甘油瓶中,裝入lmL甘油后滅菌。
將 1 mL培養(yǎng)的菌液轉(zhuǎn)移到甘油瓶中,與甘 油充分混合均勻后,放在一20 °C的冷凍 箱中保存。
聲明:本網(wǎng)站尊重并保護(hù)知識(shí)產(chǎn)權(quán),根據(jù)《信息網(wǎng)絡(luò)傳播權(quán)保護(hù)條例》,如果我們轉(zhuǎn)載的作品侵犯了您的權(quán)利,請(qǐng)?jiān)谝粋€(gè)月內(nèi)通知我們,我們會(huì)及時(shí)刪除。
蜀ICP備2020033479號(hào)-4 Copyright ? 2016 學(xué)習(xí)鳥. 頁面生成時(shí)間:3.775秒